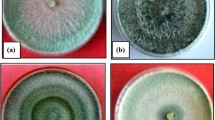

Abstract
Salt stress is one of the major abiotic stresses limiting crop growth and productivity. This work investigated the potential of five ST isolates of Trichoderma harzianum (Th-13, Th-14, Th-19, Th-33 and Th-50) applied through seed biopriming in reducing the detrimental effects of salinity stress on wheat (Triticum aestivum L.). Growth, physiological and biochemical parameters were studied to characterize salt tolerance. One factor was treatments (T1, T2, T3, T4, T5 and T6) and second factor was four levels of salt stress viz., 0, 2, 4 and 6 dsm−1. In germination test, most of the isolates (Th-14, Th-19 and Th-13) were effective in improving germination percentage and reducing RPG during salinity stress. Seedlings raised from ST Trichoderma isolates had significantly higher root and shoot lengths, CC and MSI than control at all stress levels. The treatments Th-14, Th-19 and Th-13 showed lower accumulation of MDA content whereas proline content and phenolics were higher in treated plants under both non-saline and saline conditions. Highest MDA content was observed in control at salt stress level of 6 dSm−1. It is concluded that seed biopriming with different salinity tolerant isolates of Trichoderma reduced severity of the effects of salinity though the amelioration was better in Th-14 under present experimental material and conditions.
Similar content being viewed by others
Avoid common mistakes on your manuscript.
Introduction
Salt stress is an important growth-limiting factor for most non-halophyte plants. Unfortunately, high level of salts cannot be tolerated by most crops, a fact that severely limits the use of salt affected soils. Salt affected soil is progressively being exacerbated by agronomic practices such as improper irrigation and fertilization, especially in arid regions (Villa-Castorena et al. 2003). At higher salt levels, the crop yields are reduced so drastically that crop cultivation is not economical without soil amendments. The addition of salts to water lowers its osmotic potential, resulting in decreased availability of water to roots and thus exposes plants to secondary osmotic stress. This implies that all the physiological responses associated with the drought stress can also be invoked by salt stress. The area affected by salinity in the world covers about 400 million hectares, of which 54 millions are found in South and SouthEast Asia (Akbar and Ponnamperuma 1982). In spite of the extensive literature there is still a controversy with regard to the mechanisms of salt tolerance to plants (Neumann 1995). The growth of plants is ultimately reduced by salinity stress although plant species differ in their tolerance to salinity (Munns and Termaat 1986). Successful seedling establishment depends on the frequency and the amount of precipitation as well as on the ability of the seed to germinate and grow while soil moisture and osmotic potential decrease (Roundy 1985). High levels of soil salinity can inhibit seed germination and seedling growth, due to the combined effect of high osmotic potential and specific ion toxicity (Grieve and Suarez 1997). Specific electrical conductivity (EC) above 0.8 dSm−1 at 25°C in 1:2 soil water suspension is considered to be high for salt sensitive plants and injurious to germinating seeds or seedlings of most crops while a value above 1.5 dSm−1 is considered as excessive salinity, injurious to most plants at all growth stages (Bear 1965).
Poor germination and poor seedling establishment are the results of soil salinity, which adversely affects growth and development of crop plants and results in to low agricultural production (Garg and Gupta 1997). Wheat is grown in all types of soils and is classified as a moderate, salt tolerant crop (Mass and Hoffman 1977). The effects of salinity at seedling stage of wheat range from reduction in germination percentage, fresh and dry weight of shoots and roots to the uptake of various nutrient ions. It is thought that the depressive effect of salinity on germination could be related to a decline in endogenous levels of hormones (Afzal et al. 2006). However, incorporation of Trichoderma during seed biopriming treatments in many cereal and vegetable crops has resulted in increased levels of plant growth hormones and improved seed performance (Howell 2003). Biopriming is a process of biological seed treatment that refers to a combination of seed hydration and seed inoculation with beneficial organisms to protect seed. The technique helps seeds to evenly germinate even under adverse soil conditions (Singh et al. 2003). Biocontrol agent, Trichoderma, releases a variety of compounds that induce resistance responses to biotic and abiotic stresses (Harman et al. 2004; Cardona and Rodriguez 2006). Several studies have shown that root colonization by Trichoderma harzianum results in increased level of plant enzymes, including various peroxidases, chitinases, β-1,3-glucanases, lipoxygenase-pathway hydro peroxide lyase and compounds like phytoalexins and phenols to provide durable resistance against stress (Harman 2006; Hoitink et al. 2006; Gachomo and Kotchoni 2008).
Accumulation of some compatible solutes has been observed under salt stress conditions and has been suggested as part of mechanism(s) that controls salt tolerance in plants. Proline is one of the best known solutes, however, its relative importance for tolerance and precise protective function during stress require investigations (Bohnert and Jensen 1996). Production of MDA, which is an indicative of oxidative stress, increases as salinity stress increases in plant, serves as an index of lipid peroxidation. Peroxidation damage of the plasma membrane leads to leakage of contents, rapid desiccation and cell death (Scandalios 1993).
The objective of this study was to investigate the effects of seed biopriming of wheat seeds with salinity tolerant Trichoderma strains upon their germination, subsequent growth, physiological and biochemical parameters under normal and saline conditions. In this study we have examined and compared the proline, malondealdehyde and phenol accumulation in seedlings of treated and untreated wheat seeds with different degrees of salt stress in order to exploit salinity tolerant Trichoderma strains in relation to salt stress tolerance in wheat.
This research is important as it reveals the role of Trichoderma in imparting stress resistance and provides insight in to the potential for wheat plants to adapt to saline conditions.
Materials and methods
Experimental site
The experiment was carried out during 2009–10 in Department of Plant Pathology, College of Agriculture, GBPUA&T, Pantnagar. Seeds of wheat (Triticum aestivum L.) var. RR-21 were obtained from BSPC (Breeders Seed Processing Centre), Pantnagar. Before use, seeds were surface sterilized in 1% sodium hypochlorite solution for 3 min, then rinsed with sterilized distilled water and air dried.
Seed biopriming
Five previously tested salinity tolerant isolates of Trichoderma harzianum (Th-13, Th-14, Th-19, Th-33 and Th-50) were obtained from the repository of Biocontrol Lab of Department of Plant Pathology, GBPUA & T. Seeds were treated separately with each isolate of Trichoderma spp. @ 10 g/kg of seeds. Seeds were then kept under warm and moist conditions until prior to radical emergence. The different treatments taken are given in Table 1.
Sowing and salt stress treatment
Seeds were sown in 2″ diameter plastic pots filled with soil prepared in the following manner. Bulk surface soil (0–15 cm) was collected from the CRC (Crop Research Centre), Pantnagar, which was air dried, mixed thoroughly and passed through 2-mm sieve. Plastic pots were filled with 300 g soil each. The soil was sandy loam with pH7.7 with an EC of 0.43 dSm−1. The plants were exposed to four levels of salt stress viz., 0 (0.43 dSm−1), 2, 4 and 6 dSm−1. For this purpose, stock solution of NaCl [1000 me Cl−1] was prepared. This stock solution was then added in 10 g of soil of known EC in different quantity (0.5–6 ml), then distilled water was added to get 1: 2 soil: solution ratio for recording EC of soil samples after equilibration. A calibration curve was prepared and the amount of salt required for 300 g of soil was calculated for different salt stress levels from calibration curve (Dubey and Maurya 2003). The quantity of salt calculated in this manner was mixed with soil for the development of desired levels of salt stress of 0, 2, 4 and 6 dSm−1. Specific electrical conductivity (dSm−1 at 25°C) of 1: 2 soil water suspension was taken as a criterion of salinity stress. The experiment was laid out in a completely randomized design with three replications. Ten seeds per pot were sown. The EC of the soil in plastic pots was tested at regular intervals and final salt stress level was recorded to be 0.43, 1.72, 3.84 and 5.76 dSm−1 in pots with 0, 2, 4 and 6 dSm−1 salt stress treatments, respectively at the end of the experiment. The quantity of salt taken to achieve desired level of salt stress is given in Table 2.
Observations
All the observations were recorded at 28 days after sowing (DAS) using youngest fully expanded leaf. Such leaf samples were collected from two plants per treatment per replicate.
Germination test
Reduction percentage of germination (RPG) or emergence (RPE) was calculated as quoted by Madidi et al (2004).
“ N ”x is the number of germinated seedlings under salt stress and “ Nc ” is the number of germinated seedlings under normal conditions (0 dSm−1).
Plant height
Shoot and root lengths of 28 days old seedlings were measured manually.
Total chlorophyll
The total chlorophyll content of fresh leaves was estimated following the method suggested by Barnes et al. (1992). Total chlorophyll was calculated according to the following formula:
Membrane stability index
Membrane stability index (MSI) of fresh leaves was determined as per the method suggested by Bailly et al. (1996). For this, two leaves of each treatment were randomly chosen per replicate and two leaf samples per plant were taken as follows. One sample from second leaf below the shoot apex and the second sample from third leaf above the base were taken to represent developing and mature leaves, respectively (Kaya et al. 2003). The conductivity of solution was measured using a conductivity bridge meter using the formula,
Where, C1 = conductivity at 40°C; C2 = conductivity at 100°C
Proline content
Proline content was determined following the method of Bates et al (1973). Leaf tissue (0.2 g) was homogenized in 4 ml of sulphosalicylic acid (3%) and centrifuged at 10,000 g for 30 min. About 2 ml of the supernatant was taken in a test tube and to it 2 ml of glacial acetic acid and 2 ml ninhydrin reagent were added. The reaction mixture was boiled in water bath at 100°C for 30 min. After cooling the reaction mixture, 4 ml of toluene was added and vortexed for 30 s, the upper phase containing proline was measured with spectrophotometer at 520 nm using toluene as a blank. Proline content (μmol/g fr.wt.) was quantified by the ninhydrin acid reagent method by using L-proline as a standard.
Malondialdehyde (MDA) content
Lipid peroxidation was determined by measuring the amount of MDA produced by the thiobarbituric acid reaction as described by Heath and Packer (1968).
Total phenol
Total phenol content was estimated by the method suggested by Thimmaiah (1999) using Folin –Ciocalteu reagent and the absorbance was measured at 650 nm against each blank. The content of phenol was obtained from different concentrations of catechol and expressed as mg/100 g.
Salt tolerance index amongst treatments for salt stress tolerance
To allow comparison amongst treatments, a salt sensitive treatment (Control) was chosen as susceptible standard and the performance of other treatments was compared by calculating a salt tolerance index (Zeng et al. 2003). We chose control (untreated) as susceptible standard as it had highest mean for RPG and MDA content and lower mean for other characters.
Highest salt tolerance index for different parameters was used as criteria for choosing more saline tolerant isolate of Trichoderma to alleviate salinity stress in wheat except for RPG and MDA content for which reverse order was accepted.
Statistical analyses
The experimental data were analyzed as per the procedure of two factor CRD and standard error of each mean was calculated to represent that on the bar diagram. The CD values were computed by multiplying the standard error of difference (SEd) with table t value at error degrees of freedom (Gomez and Gomez 1984).
Results
In the present study, salt stress treatments of 0, 2, 4 and 6 dsm−1 were used. Analysis of variance (Table 3) revealed significant differences amongst treatments and treatment X salt stress level interaction for all the growth, physiological and biochemical parameters except for RPG (%) and total chlorophyll content (mg/g fr.wt.).
Growth, physiological and biochemical consequences of salt stress
The growth, physiological and biochemical consequences of salt stress on different treatments were assessed in relation to germination percentage, reduction percentage of germination, shoot length, root length, total chlorophyll, MSI, proline content, MDA content and total phenols. The effect of salt injury on early seedling stage of wheat is shown in Fig. 1. The data are depicted in the form of charts (Fig. 2a-i) for the selection of treatments for different parameters, while salt tolerance index is presented in Table 4. The data indicated that plant responses to imposed salinity stress conditions were distinctly affected by different treatments of salinity tolerant Trichoderma isolates.
Effect of salt injury on early seedling stage of wheat. a, c and e showing comparative difference between Trichoderma treated and untreated seedlings at 0, 4 and 6 dsm−1 salt concentrations, respectively. b showing yellowing of seedlings due to salt injury. d showing inhibition of germination due to salt injury
Effect of seed biopriming with salinity tolerant isolates of T. harzianum on different growth, physiological and biochemical parameters of wheat grown under different levels of salt stress. a Germination (%), b RPG (%), c Shoot length (cm), d Root length (cm), e Total chlorophyll (mg/g fresh weight) f MSI (%), g Proline content (μmol/g fresh weight), h MDA content (μmol/g fresh weight), i Total phenolics (mg/100 g fresh weight)
Germination percentage and reduction percentage of germination
Seed biopriming had a significant effect on germination percentage (GP) and reduction percent of germination (RPG) under saline conditions (Fig. 2a and b). Under normal conditions (0 dSm−1), maximum germination (100%) was achieved in seeds primed with Th-14, which was statistically similar to all the remaining treatments including control. Under saline conditions, maximum germination (mean at salt stress = 91.66) with salt tolerance index of 1.87 and minimum reduction percentage of germination (mean at salt stress = 11.11) with salt tolerance index of 0.20 was observed in seeds primed with Th-14 followed by Th-19 (index 1.62 and 0.50 in GP and RPG, respectively). Minimum germination percentage (mean at salt stress = 61.66) and maximum reduction percentage of germination (mean at salt stress = 43.88) were observed in untreated seeds (control) at all stress levels with salt tolerance index of 1.00 in each. Under normal conditions (0 dSm−1), Th-14 generally had little effect on germination. However, under stress, treated seeds germinated consistently faster and more uniformly than untreated seeds.
Shoot and root length
Shoot length and root length were high for all treatments including control at normal conditions (0 dSm−1). The shoot length and root length decreased as salt stress increased. The shoot and root length reduced to almost more than 50% from 8.80 cm and 5.80 cm, respectively at 0 dSm−1 to 3.36 cm and 2.20 cm, respectively at 6 dSm−1 in untreated plants (control). However, it could be noted that seedlings obtained from seeds bioprimed with different Trichoderma isolates had significantly higher shoot and root length than control under both normal and salt stress conditions (Fig. 2c and d). Maximum shoot and root length were recorded in treatment Th-14 (8.56 cm and 6.14 cm, respectively) followed by Th-19 (8.07 cm and 5.94 cm, respectively) considering the mean at salt stress. Data in Table 4 indicates that the salt stress tolerance index for shoot and root length was highest in Th-14 (index 1.45 and index 1.61, respectively) followed by Th-19 (index 1.34 and index 1.56, respectively) and Th-13 (index 1.26 and index 1.43, respectively). The minimum salt tolerance index for shoot and root length was observed in control (index 1.00 in each) followed by Th-50 (index1.21 and 1.33, respectively) and Th-33 (index 1.22 and 1.43, respectively).
Total chlorophyll
The total chlorophyll content of leaves averaged over treatments indicated that it decreased (from 2.63 mg/g at 0 dSm−1 to 1.62 mg/g at 6 dSm−1) significantly with increase in salt concentrations. The highest chlorophyll content under salt stress was recorded in treatment Th-14 (2.41 mg/g) closely followed by Th-19 (2.27 mg/g), Th-13 (2.181 mg/g) and Th-33(2.06 mg/g) considering mean at salt stress (Fig. 2e). Among salinity tolerant Trichoderma isolates minimum chlorophyll content was recorded in Th-50 (mean at salt stress = 1.96 mg/g), which was higher than that in control (mean at salt stress = 1.84 mg/g). The maximum salt tolerance index was observed for Th-14 (index 1.36) followed by Th-19 (index 1.28), Th-13 (index 1.21) and Th-33 (index 1.14). Whereas minimum index (1.00) was recorded in control (untreated plants) followed by Th-50 (index 1.08) as shown in Table 4.
Membrane stability index
Membrane stability index (MSI) was high for all treatments under normal (0 dSm−1) conditions. The MSI decreased significantly as salt stress increased from 0 to 6 dSm−1. The MSI value was reduced to almost two fold under 6 dSm−1 (38.04%) from 0 dSm−1 (84.74%), considering the mean MSI of all treatments. The treatments had higher MSI (82.64–86.21%) under normal conditions, while under salt stress treatments showed reduced MSI (53.21–63.34%, considering mean at salt stress). The different treatments differed significantly under salt stress conditions. Salt stress caused a severe loss in membrane stability in untreated plants. Under salt stress, the highest MSI was recorded in Th-14 (63.34%) closely followed by Th-19 (63.27) and Th-13 (58.79%) (Fig. 2f). The MSI was lowest in T1 (control) followed by Th-50 and Th-33 (50.78%, 53.21% and 56.35%, respectively). The salt tolerance index (Table 4) revealed highest value for treatments Th-14 and Th-19 (1.34 each) while lowest salt tolerance index (1.00) was recorded in treatment T1 (control) followed by Th-50 (1.08) and Th-33 (1.11).
Proline content
Proline content was significantly influenced by both salt stress and Trichoderma treatments. The proline content of leaves increased at higher salt stress level of 6 dSm-1 (17.34 μmol/g) compared with 0 dSm-1 (3.01 μmol/g) in all the treatments. Treatment, Th-14 had accumulated maximum proline content (mean at salt stress = 14.54 μmol/g) followed by Th-13 (12.49 μmol/g) and Th-19 (11.44 μmol/g) under salt stress (Fig. 1g). While minimum proline content was recorded in control (3.98 μmol/g) followed by Th-50 and Th-33 (8.65 μmol/g and 9.55 μmol/g respectively) at all stress levels. Considering mean value of salt stress, Th-14 exhibited approximately four fold maximum proline content as compared to the control (untreated), however this fluctuation was less dramatic among the Trichoderma treatments. The indices of proline content ranged from 1.00 to 3.37 among treatments. The highest salt tolerance index (index 3.37) was observed in Th-14 followed by Th-19 (index 2.90) and Th-13 (index 2.65) while the lowest one (index 1.00) was recorded in control.
Malondealdehyde (MDA) content
The rate of lipid peroxidation was determined by measuring the amount of malondealdehyde content, a natural product of oxidation of polyunsaturated fatty acids present in the membrane caused by accumulation of free oxygen radicals. The MDA content was higher in T1 (control) at all stress levels (Fig. 2h) from 0 dSm−1 (1.93 μmol/g) to 6 dSm−1 (7.80 μmol/g ) with index 1.00 followed by Th-50 (1.70 μmol/g at 0 dSm−1 to 5.36 μmol/g at 6 dSm−1) with index 0.75 and Th-33 (1.78 μmol/g at 0 dSm−1 to 3.70 μmol/g at 6 dSm−1) with index 0.74 indicating higher rate of lipid per oxidation due to salt stress. The accumulation of MDA content was lowest in treatment Th-14 (mean at salt stress = 2.07 μmol/g), which was followed by Th-19 (mean at salt stress = 2.68 μmol/g) with the indices of 0.48 and 0.61, respectively revealing reduced accumulation of lipid peroxides in seedlings from Th-14 and Th-19 treated seeds under osmotic stress.
Phenol content
The phenol content increased substantially with an increase in salt stress level. Treatments differed significantly both under normal (0 dSm−1) and salt stress conditions (6 dSm−1). A significantly higher level of phenol content was found in Trichoderma treated plants as the salt stress increased from 0 dSm−1 to 6 dSm−1 in comparison to untreated plants. Highest phenol content under salt stress was observed in treatment Th-14 (6.55 mg/100 g) followed by Th-19 (5.71 mg/100 g) and Th-13(5.29 mg/100 g) considering mean at salt stress (Fig. 2i) with salt tolerance indices of 2.55, 2.20 and 2.05, respectively. Among all treatments, T1 (control) showed minimum phenol content (mean at salt stress = 2.57 mg/100 g) with the lowest salt tolerance index of 1.00 followed by Th-50 (4.60 mg/ 100 g, considering mean at salt stress) with salt tolerance index of 1.76 as given in Table 4.
Discussion and conclusion
Salt stress is an important abiotic factor limiting crop productivity. It is an intricate phenomenon involving osmotic stress, specific ion effect, nutrient deficiency, etc. thereby affecting different physiological and biochemical mechanisms related to plant growth and development. Among several strategies used to improve crop growth under salt stress, use of salinity tolerant Trichoderma isolates through seed biopriming could be an effective and easily adaptive strategy. To improve the efficiency of such strategies and to develop newer options, a better understanding of the physiological and molecular bases of salt tolerance in plants is required. Several classes of endophytic microorganisms, in addition to Trichoderma species, are known to alter the response of plants to abiotic stresses. Among several mechanisms employed by Trichoderma to enhance salinity tolerance, the most studied mechanism relates to Trichoderma-induced significant changes in the plant metabolic machinery, which in most cases, benefits the plant (Harman et al. 2004). For the present investigation different salt induced parameters were taken into consideration that were supposed to be influenced by Trichoderma inoculation under salt stress in order to investigate the effects of different salinity tolerant isolates of Trichoderma harzianum on physiological and biochemical responses of wheat under salt stress. The present study led to demonstrate a highly significant effect of seed biopriming with Th-14, a salinity tolerant isolate of Trichoderma harzianum, to alleviate salt stress.
Growth, physiological and biochemical parameters
Analysis of variance for different growth, physiological and biochemical parameters in the present research was significant indicating the differential response of treatments to different salt stress levels. The salt tolerance indexing also indicated a substantial variation in the experimental material for salt tolerance.
In the present study, salt stress caused significant decrease in germination and seedling growth of wheat in untreated plants. These results are in agreement with those obtained by other authors, showing that in wheat, germination is significantly decreased by salinity (Sarin and Narayanan 1968; Ashraf and O’leary 1997). It could be that NaCl reduced the rate of germination due to the reduced water potential and the resulting slower rate of imbibitions. High amounts of NaCl disturbed the ionic balance of plant cells and also caused imbalances in plant nutrients, which affected the germination percentage and plant growth (Hadas 1977). From the present investigation, it is quite clear that seeds bioprimed with various salinity tolerant Trichoderma isolates proved to be effective as compared to control (untreated) in inducing salt tolerance at the germination stage and seedling growth in wheat at all stress levels. It is well documented that seed biopriming with Trichoderma improves seed performance and helps seeds to germinate even under adverse soil conditions (Singh et al. 2003). Trichoderma releases a variety of compounds that induce resistance response to biotic and abiotic stresses (Harman et al. 2004). The results related to germination percentage can be related to earlier findings in which it was reported that seed treatment with Trichoderma increases the germination percentage and rate of germination (Benitez et al. 2004).
It is possible that decrease in the shoot and root growth in salinized plants could be due to several reasons. One possibility is that salinity reduces photosynthesis, which in turn limits the supply of carbohydrates needed for growth. Secondly, salinity reduces shoot and root growth by reducing sugars in expanding tissues resulting from lowered water potential in root growth medium. Third possibility is that the root response to salinity was to down-regulate shoot growth via a long distance signal (Alam et al. 2004 ). Fourth, a disturbance in mineral supply, either on excess or deficiency, induced by changes in concentrations of specific ions in the growth medium might have directly affected growth (Lazof and Bernstein 1998). However, plants obtained from bioprimed seeds showed higher shoot and root length. These results are in agreement with those of other workers (Howell 2003; Benitez et al. 2004), who reported that Trichoderma strains produce plant growth hormones like cytokinin-like molecules, e.g. zeatin and gibberellin GA3 or GA3-related. The application of Trichoderma strains in plants increases deep roots, which helps in more water acquisition and thereby increasing the plants ability to resist abiotic stresses (drought, salt etc) and uptake of nutrients (Arora et al. 1992). Furthermore, the problem of soil salinity rarely occurs in isolation. Mineral deficiencies and ion toxicities frequently compound the problem of salinity. It is well proved that Trichoderma increases plant height or shoot biomass. Plant growth vigor, e.g. plant height or shoot biomass has been reported to have dilution effects on sodium accumulation in leaves of plants (Yeo et al. 1990). Trichoderma can also solubilize various plant nutrients such as rock phosphate, Fe3+, Cu2+, Mn4+ and metallic Zn that can be unavailable to plants in certain soils. Trichoderma reduces oxidized metallic ions to increase their solubility and thus their availability to plants (Harman et al. 2004).
Plants exposed to saline environment generally have the chlorophyll content reduced. NaCl stress decreased total chlorophyll content of the plant by increasing the activity of the chlorophyll degrading enzyme: chlorophyllase (Rao and Rao 1981), inducing the destruction of the chloroplast structure and the instability of pigment complexes (Singh and Dubey 1995). It has been demonstrated that chlorophyll content decreases in salt susceptible plants such as tomato (Lapina and Popov 1970), pea (Hamada and El-Enany 1994) and soybean (Seeman and Critchley 1985). In the present study, maximum total chlorophyll content was recorded in Th-14 treated plants while minimum in control (untreated) plants under both normal and salt stress conditions. However, the decrease in total chlorophyll content with increased salinity was observed in all the treatments.
The results on MSI showed a decreasing trend with the increase in salt concentration. The presence of NaCl in the rooting medium caused a disturbance in membrane permeability expressed by an increase in solute leakage (Ghoulam et al. 2002). The leakage was higher in untreated plants than Trichoderma treated plants, indicating severe membrane damage in the former under salt stress. The higher leakage of solutes was probably due to enhanced H2O2 accumulation and lipid per oxidation under salt stress (Dionisio-Sese and Tobita 1998). An important consequence of salt stress is the generation of ROS (reactive oxygen species). These oxidants, formed under salt stress, cause membrane disorganization and metabolic toxicity, resulting in higher leakage of solutes. The leakage was lowest in Th-14 treated plants. Harman (2006) also concluded that root colonization by Trichoderma harzianum strain T-22 resulted in enhanced concentration of antioxidant enzymes (like peroxidases, chitinases, etc). These antioxidant enzymes act as scavengers of ROS and thus cause membrane stability.
The accumulation of proline under salt stress protects the cell by balancing the osmotic level of cytosol with that of vacuole and external environment (Gadallah 1999; Greenway and Munns 1980). Besides, these solutes interact with cellular macromolecules such as enzymes and stabilize their structure and functions (Smirnoff and Cumbes 1989). The higher osmolyte concentration in Th-14 under salt stress helped maintain structure and function of cellular macromolecules. It has been reported that higher osmolyte concentration helps in the maintenance of comparatively higher relative water content and antioxidant enzyme activity (Smirnoff and Cumbes 1989). In cucumber (Botia et al. 2005; Shiqing et al. 2006) and in melon (Villora et al. 1998), similar trends of increase in proline with increase in salt concentration were reported. However, proline accumulation cannot be used as a sole criterion for salt tolerance, as it also accumulates under other stresses such as high temperature, drought and starvation (Hong et al. 2000).
The MDA, which is indicative of oxidative stress, increased as salinity stress increased in plants. Lipid peroxidation is the main index of the increase in active free radicals, and MDA is the main by-product of the lipid peroxidation process. Our findings showed that the degree of accumulation of MDA was higher in the untreated plants as compared to treated plants. Degree of accumulation of MDA content has been reported to be indicative of the rate of lipid peroxidation due to salt stress (Meloni et al. 2003; Bor et al. 2003). As lipid peroxidation is the symptom mostly ascribed to oxidative damage, it is often used as an indicator of increased damage (Hernandez et al. 2000; Khan and Panda 2008). Lowest MDA content was recorded in Th-14 (mean at salt stress = 2.07 μmol/g fr.wt), which might be due to an increase in expression of stress related proteins such as, glutathione S- transferase (GST), glutathione-dependent formaldehyde dehydrogenase (FALDH) and peroxidase. Similar effect was observed by the inoculation of Trichoderma isolate T-22 in maize plants (Harman et al. 2004). Under conditions of environmental stress, when ROS are produced, these detoxifying proteins triggered by Trichoderma inoculation act as scavenging enzymes and play a central role in protecting the cell from oxidative damage.
The results on phenol content showed an increasing trend with increase in salt stress. Maximum phenol content was observed in plants treated with Th-14 (6.55 mg/100 g) with highest salt tolerance index. Total phenolics were positively influenced by different Trichoderma treatments. Our results are supported by previous results, which showed that root colonization by Trichoderma harzianum resulted in increased levels of plant enzymes, including various peroxidases, chitinases and compounds like phytoalexins and phenolics (Hoitink et al. 2006; Gachomo and Kotchoni. 2008). Trichoderma strains, thus, not only produce metabolites directly, but also strongly stimulate plants to produce their own defense compounds. The addition of Trichoderma led to a transient increase in phenolic glucoside levels in cucumber (Benitez et al. 2004). The phenolic compounds, besides having antifungal, antibacterial and antiviral activities also possess antioxidant properties and thus act as scavengers of activated free radicals.
Our results indicate that salinity tolerant isolates of Trichoderma harzianum play critical role in plant response to salinity, which might be due to the fact that Trichoderma colonizes and penetrates root tissues and initiates a series of morphological and biochemical changes in the plant. The resulting plant mediated mechanism enhances natural defenses against any biotic and abiotic stresses. The overall positive effect of seed biopriming with Trichoderma resulted in improved germination and seedling establishment. Biopriming technique facilitates Trichoderma to enhance its colonization and number by almost hundred times on spermosphere during the period of incubation in warm and moist conditions (Singh et al. 2003). Roots obtained from these bioprimed seeds get colonized by Trichoderma, the resulting root-fungus association stimulates plant defense mechanism. In Arabidopsis thaliana, root colonization by Trichoderma isolate T 34 primed the leaf tissue for enhanced jasmonic acid-responsive genes expression and increased formation of callose containing papillae, which points to the induction of resistance mechanisms similar to the hypersensitive response (HR), systemic acquired resistance (SAR) and induced systemic resistance (ISR) in plants. It has also been reported that root specific transcription factor MYB72 is essential in early signaling steps of ISR. It functions as an early node of convergence in the signaling pathways that are induced by Trichoderma (Segarra et al. 2009). At molecular level the resistance results in an increase in the concentration of metabolites and enzymes related to defensive mechanisms, such as the enzyme phenyl-alanine ammonio-lyase (PAL) and chalcone synthase (CHS), involved in the biosynthesis of phytoalexins, chitinases, glucanases and peroxidases. These comprise metabolites and enzymes involved in the plant response to oxidative stress. Thus, plant protection seems to result exclusively from increase in enzymatic activities (Benitez et al. 2004). Plants pretreated with Trichoderma, thus, respond to salinity stress by modulating physiological and biochemical parameters, which ultimately leads to the restoration of cellular homeostasis, detoxification of toxins and recovery of growth. The signal transduction pathways mediating these adaptations can be examined by combining forward and reverse approaches with molecular, biochemical and physiological studies.
The present research, thus, offers a new approach to alleviate salinity stress in wheat through seed biopriming with salinity tolerant Trichoderma strains. It could be concluded that seed biopriming with Trichoderma harzianum strain Th-14 increased the ability of wheat to grow successfully under saline conditions and salt tolerance index revealed variability for salt tolerance amongst different Trichoderma isolates. Th-14 was considered best in providing salinity tolerance on the basis of high salt tolerance index for all physiological and biochemical traits studied except for MDA content and RPG, for which it was the lowest, leaving open the possibility that seed biopriming with Th-14 might pre-adapt plants to salinity stress. Research on new isolates of Trichoderma more tolerant to salt would help select more performing strains to be used through seed biopriming to alleviate salt stress in crops where salinity of soils constitutes a factor reducing crop productivity. It would be necessary to study the adaptation of these strains to saline soil conditions before introducing them in different environments. Knowing the mechanism that underlies the plants salt stress response to Trichoderma inoculation could be useful in designing new growth enhancement strategies using Trichoderma in saline soils. Finally, in future, these seed biopriming treatments could be used for improving plant growth and yield of this important crop in saline areas.
Abbreviations
- ST:
-
Salinity tolerant
- RPG:
-
Reduction percentage of germination
- CC:
-
Chlorophyll content
- MSI:
-
Membrane stability index
- MDA:
-
Malondialdehyde
References
Afzal I, Basra SMA, Farooq M, Nawaz A (2006) Alleviation of salinity stress in spring wheat by hormonal priming with ABA, salicylic acid and ascorbic acid. Int J Agri Biol 8:23–28
Akbar M, Ponnamperuma FN (1982) Saline soil of South and Southeast Asia potential rice lands. In: Riche Strategies for the Future. IRRI, Los Banos, Philippines, pp 265-281
Alam MZ, Stuchbury T, Naylor REL, Rashid MA (2004) Effect of salinity on growth of some modern rice cultivars. J Agron 3:1–10
Arora DK, Elander RP, Mukherji KG (1992) In: Fungal biotechnology. Handbook of applied mycology. Markel Dekker, New York, p 4
Ashraf M, O’leary JM (1997) Ion distribution in leaves of salt-tolerant and salt-sensitive lines of spring wheat under salt stress. Acta Bot Neerl 46:207–217
Bailly C, Benamar A, Corbineau F, Cone D (1996) Changes in malondialdehyde content and in superoxide dismutase, catalase and glutathione reductase activities in sunflower seeds as related to deterioration during accelerated aging. Physiol Plant 97:104–110
Barnes JD, Balaguer L, Manrigue E, Elivira S, Davison AW (1992) A reappraisal of the use of DMSO for the extraction of chlorophyll a and b in lichens and higher plants. Environ Exp Bot 32:85–90
Bates LS, Waldron RP, Teare ID (1973) Rapid determination of free proline in water stress studies. Plant Soil 29:205–208
Bear FE (1965) Chemistry of the soil. Oxford IBH Publishing, New Delhi, p 501
Benitez T, Rincon AM, Limon MC, Codon AC (2004) Biocontrol mechanisms of Trichoderma strains. Int Microbiol 7:249–260
Bohnert HJ, Jensen RG (1996) Strategies for engineering water stress tolerance in plants. Trends Biotechnol 14:89–97
Bor M, Ozdemir F, Turkan I (2003) The effect of salt stress on lipid peroxidation and antioxidants in leaves of sugar beet Beta vulgaris L. and wild beet Beta maritime L. Plant Sci 164:77–84
Botia P, Navarro JM, Cerda A, Martinez V (2005) Yield and fruit quality of two melon cultivars irrigated with saline water at different stage of development. Eur J Agron 23:243–253
Cardona R, Rodriguez H (2006) Effects of Trichoderma harzianum fungus on the incidence of the charcoal rot disease on sesame. Rev Fac Agron (LUZ) 23:42–47
Dionisio-Sese ML, Tobita S (1998) Antioxidant responses of rice seedlings to salinity stress. Plant Sci Limerick 135:1–9
Dubey SK, Maurya IZ (2003) Studies on heterosis and combining ability in bottle gourd. Indian J Genet Plant Breed 63:148–152
Gachomo EW, Kotchoni SO (2008) The use of T. harzianum and T. viride as potential biocontrol agents against peanut microflora and their effectiveness in reducing aflatoxin contamination of infected kernels. Biotechnology 7:439–447
Gadallah MAA (1999) Effect of proline and glycine-betaine on Vicia faba in response to salt stress. Biol Plant 42:247–249
Garg BK, Gupta IC (1997) Plant relations to salinity. In: Saline wastelands environment and plant growth. Scientific Publishers, Jodhpur, pp 79–121
Ghoulam C, Ahmed F, Khalid F (2002) Effects of salt stress on growth, inorganic ions and proline accumulation in relation to osmotic adjustment in five sugar beet cultivars. Environ Exp Bot 47:39–50
Gomez KA, Gomez AA (1984) Statistical procedures for agricultural research. Wiley, New York
Greenway H, Munns H (1980) Mechanisms of salt tolerance in nonhalophytes. Annu Rev Plant Physiol 31:149–190
Grieve CM, Suarez DL (1997) Purslane (Portulaca oleracea L.): a halophytic crop for drainage water reuse systems. Plant and Soil 192:277–283
Hadas A (1977) Water uptake and germination of leguminous seeds in soils of changing matrix and osmotic water potential. J Exp Bot 28:977–985
Hamada AM, EL-Enany AE (1994) Effect of NaCl salinity on growth, pigment and mineral element contents, and gas exchange of broad bean and pea plants. Biologia Plantarum 36:75–81
Harman GE (2006) Overview of mechanisms and uses of Trichoderma spp. Phytopathology 96:190–194
Harman GE, Howell CR, Vitarbo A, Chet I, Lorito M (2004) Trichoderma species –opportunistic, avirulent plant symbionts. Nature Rev Microbiol 2:43–56
Heath RL, Packer L (1968) Photoperoxidation in isolated chloroplasts: Kinetics and stoichiometry of fatty acid peroxidation. Arch Biochem Biophys 125:189–198
Hernandez JA, Mullineaux P, Sevilla F (2000) Tolerance of pea (Pisum sativum L.) to long term stress is associated with induction of antioxidant defences. Plant Cell Environ 23:853–862
Hoitink HAJ, Madden LV, Dorrance AE (2006) Systemic resistance induced by Trichoderma spp.: Interactions between the host, the pathogen, the biocontrol agent, and soil organic matter quality. Phytopathology 96:186–189
Hong ZL, Lakkineni K, Zhang ZM, Verma DPS (2000) Removal of feedback inhibition of delta (1)-pyrroline-5-carboxylate synthetase results in increased proline accumulation and protection of plants from osmotic stress. Plant Physiol 122:1129–1136
Howell CR (2003) Mechanisms employed by Trichoderma species in the biological control of plant diseases: the history and evolution of current concepts. Plant Dis 87:4–10
Kaya C, Higgs D, Ince F, Amador BM, Cakir A, Sakar E (2003) Ameliorative effects of potassium phosphate on salt stressed pepper and cucumber. J Plant Nutr 26:807–820
Khan MH, Panda SK (2008) Alterations in root lipid peroxidation and antioxidative responses in two rice cultivars under NaCl-salinity stress. Acta Physiol Plant 30:91–89
Lapina LP, Popov BA (1970) Effect of sodium chloride on photosynthetic apparatus of tomatoes. Fiziologiya Rastenii 17:580–584
Lazof DB, Bernstein N (1998) The NaCl induced inhibition of shoot growth: the case of disturbed nutrition with special consideration of calcium nutrition. Adv Bot Res 29:113–189
Madidi SE, Baroudi BE, Aameur FB (2004) Effects of salinity on germination and early growth of barley (Hordeum vulgare L.) cultivars. Int J Agric Biol 6:767–770
Mass EV, Hoffman GJ (1977) Crop salt tolerance -current assessment. J Irrig Drain 103:115–134
Meloni DA, Oliva AA, Martinez ZA, Cambraia J (2003) Photosynthesis and activity of superoxide dismutase, peroxidase and glutathione reductase in cotton under salt stress. Environ Exp Bot 49:69–76
Munns R, Termaat A (1986) Whole plant responses to salinity. Aust J Plant Physiol 13:143–160
Neumann PM (1995) The role of cell wall adjustment in plant resistance to water deficits. Crop Sci 35:1258–1266
Rao GG, Rao GR (1981) Pigment composition and chlorophyllase activity in pigeon pea (Cajanus indicus Spreng) and gingelley (Sesamum indicum L.) under NaCl salinity. Indian J Exp Biol 19:768–770
Roundy BA (1985) Root penetration and shoot elongation of tall wheatgrass and basin wild rye in relation to salinity. Can J Plant Sci 65:335–343
Sarin MN, Narayanan A (1968) Effects of soil salinity and growth regulators on germination and seedling metabolism in wheat. Physiol Pl 21:1201–1209
Scandalios JG (1993) Oxygen stress and superoxide dismutase. Plant Physiol 101:7–12
Seeman JR, Critchley C (1985) Effects of salt stress on the growth, ion content, stomatal behaviour and photosynthetic capacity of a salt-sensitive species, Phaseolus vulgaris L. Planta 164:151–162
Segarra G, Van der Ent S, Trillas I, Pieterse CMJ (2009) MYB72, a node of convergence in induced resistance in induced systemic resistance triggered by a fungal and a bacterial beneficial microbe. Plant Biol 11:90–96
Shiqing S, Shirong G, Qingmao S, Zhigang Z (2006) Physiological effects of exogenous salicylic acid on cucumber seedling under salt stress. Acta Hortic Sin 33:68–72
Singh AK, Dubey RS (1995) Changes in chlorophyll a and b contents and activities of photosystems 1 and 2 in rice seedlings induced by NaCl. Photosynthetica 31:489–499
Singh US, Zaidi NW, Joshi D, Varshney S, Khan T (2003) Current status of Trichoderma as a biocontrol agent. In: Ramanujam B, Rabindra RJ (eds) Current status of biological control of plant diseases using antagonistic organisms in India. Project Directorate of Biological Control, Bangalore, pp 13–48
Smirnoff N, Cumbes QJ (1989) Hydroxyl radical scavenging activity of compatible solutes. Phytochemistry 28:1057–1060
Thimmaiah SK (1999) Standard methods of biochemical analysis. Kalyani Publishers, Ludhiana, p 545
Villa-Castorena M, Ulery AL, Valencia EAC, Remmenga MD (2003) Division S-4-soil fertility and plant nutrition. Soil Sci Soc Am J 67:1781–1789
Villora G, Pulgar G, Moreno DA, Romero L (1998) Plant nitrogen characteristics of a semi-salt- tolerant zucchini variety to sodium chloride treatments. J Plant Nutr 21:2343–2355
Yeo AR, Yeo ME, Flowers TJ (1990) Screening of rice (Oryza sativa L.) genotypes for physiological characters contributing to salinity resistance, and their relationship to overall performance. Theor Appl Genet 79:337–384
Zeng L, Poss JA, Wilson C, Draz A, Gregorio GB, Grieve CM (2003) Evaluation of salt tolerance in rice genotypes by physiological characters. Euphytica 129:281–292
Acknowledgements
Thanks are due to P.C. Srivastava and N.W. Zaidi for their suggestions in the conduct of the study.
Author information
Authors and Affiliations
Corresponding author
Additional information
Responsible Editor: Hans Lambers.
Rights and permissions
About this article
Cite this article
Rawat, L., Singh, Y., Shukla, N. et al. Alleviation of the adverse effects of salinity stress in wheat (Triticum aestivum L.) by seed biopriming with salinity tolerant isolates of Trichoderma harzianum . Plant Soil 347, 387–400 (2011). https://doi.org/10.1007/s11104-011-0858-z
Received:
Accepted:
Published:
Issue Date:
DOI: https://doi.org/10.1007/s11104-011-0858-z